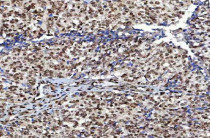

ARG44177
anti-NUDCD1 antibody
anti-NUDCD1 antibody for ICC/IF,IHC-Formalin-fixed paraffin-embedded sections,Western blot and Human,Mouse,Rat
概述
| 产品描述 | Rabbit Polyclonal antibody recognizes NUDCD1 |
|---|---|
| 反应物种 | Hu, Ms, Rat |
| 应用 | ICC/IF, IHC-P, WB |
| 宿主 | Rabbit |
| 克隆 | Polyclonal |
| 同位型 | IgG |
| 靶点名称 | NUDCD1 |
| 抗原物种 | Human |
| 抗原 | Recombinant protein of Human NUDCD1 |
| 偶联标记 | Un-conjugated |
| Protein Full name | NudC domain-containing protein 1 |
| 別名 | NUDCD1; NudC Domain Containing 1; CML66; Chronic Myelogenous Leukemia Tumor Antigen 66; NudC Domain-Containing Protein 1; Tumor Antigen CML66; FLJ14991; OVA66 |
应用说明
| 应用建议 |
|
||||||||
|---|---|---|---|---|---|---|---|---|---|
| 应用说明 | * The dilutions indicate recommended starting dilutions and the optimal dilutions or concentrations should be determined by the scientist. |
属性
| 形式 | Liquid |
|---|---|
| 纯化 | Affinity purification with immunogen. |
| 缓冲液 | 0.9% NaCl, 0.2% Na2HPO4, 0.05% Sodium azide and 5% BSA. |
| 抗菌剂 | 0.05% Sodium azide |
| 稳定剂 | 5% BSA |
| 浓度 | 0.5 mg/ml |
| 存放说明 | For continuous use, store undiluted antibody at 2-8°C for up to a week. For long-term storage, aliquot and store at -20°C or below. Storage in frost free freezers is not recommended. Avoid repeated freeze/thaw cycles. Suggest spin the vial prior to opening. The antibody solution should be gently mixed before use. |
| 注意事项 | For laboratory research only, not for drug, diagnostic or other use. |
生物信息
| 数据库连接 | |
|---|---|
| 基因名称 | NUDCD1 |
| 全名 | Nudc Domain Containing 1 |
| 背景介绍 | Predicted to be involved in immune system process. Located in cytosol and nucleoplasm. |
| 生物功能 | Isoform 1 is the dominant immunogenic isoform and is capable of eliciting a humoral response in individuals with a variety of solid tumors. Expression of isoform 1 in a wide variety of malignancies as well as the presence of an immunogenic epitope suggest that it may be a suitable target for antigen-specific immunotherapy. |
| 细胞定位 | Cytoplasm, Nucleus |
| 预测分子量 | 67 kDa |
| 翻译后修饰 | Phosphoprotein |
检测图片 (6) Click the Picture to Zoom In
-
ARG44177 anti-NUDCD1 antibody IHC-P image
Immunohistochemistry: Human lung cancer stained with ARG44177 anti-NUDCD1 antibody at 2 μg/mL dilution.
-
ARG44177 anti-NUDCD1 antibody ICC/IF image
Immunofluorescence: HeLa stained with ARG44177 anti-NUDCD1 antibody at 5 μg/mL dilution.
-
ARG44177 anti-NUDCD1 antibody WB image
Western blot: A549 and K562 stained with ARG44177 anti-NUDCD1 antibody at 0.5 μg/mL dilution.
-
ARG44177 anti-NUDCD1 antibody WB image
Western blot: C6 stained with ARG44177 anti-NUDCD1 antibody at 0.5 μg/mL dilution.
-
ARG44177 anti-NUDCD1 antibody IHC-P image
Immunohistochemistry: Human ovarian cancer stained with ARG44177 anti-NUDCD1 antibody at 2 μg/mL dilution.
-
ARG44177 anti-NUDCD1 antibody WB image
Western blot: COS-7 stained with ARG44177 anti-NUDCD1 antibody at 0.5 μg/mL dilution.